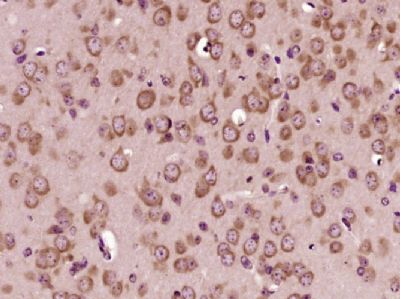
产品封面图

相关产品推荐更多 >
万千商家帮你免费找货
0 人在求购买到急需产品
- 详细信息
- 文献和实验
- 技术资料
- 供应商:
上海康朗生物科技有限公司
- 库存:
大量
- 目录编号:
kl-14276R
- 克隆性:
多克隆
- 抗原来源:
Rabbit
- 保质期:
12个月
- 抗体英文名:
Density Regulated Protein antibody
- 抗体名:
密度调节蛋白抗体
- 宿主:
Rabbit
- 适应物种:
Human, Mouse, Rat, Chicken, Dog, Pig, Cow, Horse, Sheep,
- 免疫原:
KLH conjugated synthetic peptide derived from human Density Regulated Protein:51-150/198
- 亚型:
IgG
- 形态:
冻干粉或液体
- 应用范围:
WB=1:500-2000 ELISA=1:500-1000 IHC-P=1:400-800 IHC-F=1:400-800 ICC=1:100-500 IF=1:100-500
- 浓度:
1mg/ml
- 保存条件:
-20 °C
- 规格:
100ul 200ul
| 中文名称 | 密度调节蛋白抗体 |
| 别 名 | denr; DENR_HUMAN; Density regulated protein; Density-regulated protein; DRP; DRP1; DRP1 protein; Protein DRP1; SMAP-3; SMAP3; Smooth muscle cell associated protein 3; Smooth muscle cell-associated protein 3. |
| 规格价格 | 100ul/1380元 购买 200ul/2200元 购买 大包装/询价 |
| 说 明 书 | 100ul 200ul |
| 研究领域 | 肿瘤 转运蛋白 表观遗传学 |
| 抗体来源 | Rabbit |
| 克隆类型 | Polyclonal |
| 交叉反应 | Human, Mouse, Rat, Chicken, Dog, Pig, Cow, Horse, Sheep, |
| 产品应用 | WB=1:500-2000 ELISA=1:500-1000 IHC-P=1:400-800 IHC-F=1:400-800 ICC=1:100-500 IF=1:100-500 (石蜡切片需做抗原修复) not yet tested in other applications. optimal dilutions/concentrations should be determined by the end user. |
| 分 子 量 | 22kDa |
| 性 状 | Lyophilized or Liquid |
| 浓 度 | 1mg/ml |
| 免 疫 原 | KLH conjugated synthetic peptide derived from human Density Regulated Protein:51-150/198 |
| 亚 型 | IgG |
| 纯化方法 | affinity purified by Protein A |
| 储 存 液 | 0.01M TBS(pH7.4) with 1% BSA, 0.03% Proclin300 and 50% Glycerol. |
| 保存条件 | Store at -20 °C for one year. Avoid repeated freeze/thaw cycles. The lyophilized antibody is stable at room temperature for at least one month and for greater than a year when kept at -20°C. When reconstituted in sterile pH 7.4 0.01M PBS or diluent of antibody the antibody is stable for at least two weeks at 2-4 °C. |
| PubMed | PubMed |
| 产品介绍 | background: This gene encodes a protein whose expression was found to increase in cultured cells at high density but not during growth arrest. This gene was also shown to have increased expression in cells overexpressing HER-2/neu proto-oncogene. The protein contains an SUI1 domain. In budding yeast, SUI1 is a translation initiation factor that along with eIF-2 and the initiator tRNA-Met, directs the ribosome to the proper translation start site. Proteins similar to SUI have been found in mammals, insects, and plants. [provided by RefSeq, Jul 2008] Function: May be involved in the translation of target mRNAs by scanning and recognition of the initiation codon. Plays a role in the modulation of the translational profile of a subset of cancer-related mRNAs when recruited to the translational initiation complex by the oncogene MCTS1. Tissue Specificity: Highly expressed in heart and skeletal muscle and moderately expressed in the brain, placenta, liver and pancreas. Weakly expressed in the lung and kidney. Similarity: Belongs to the DENR family. Contains 1 SUI1 domain. SWISS: O43583 Gene ID: 8562 Database links: Entrez Gene: 8562 Human Entrez Gene: 771794 Chicken Entrez Gene: 614238 Cow Entrez Gene: 68184 Mouse Entrez Gene: 360806 Rat Entrez Gene: 444615 Xenopus laevis Omim: 604550 Human SwissProt: Q5ZJ39 Chicken SwissProt: Q2HJ47 Cow SwissProt: O43583 Human SwissProt: Q9CQJ6 Mouse SwissProt: Q6GLZ1 Xenopus laevis SwissProt: Q6DFN7 Xenopus tropicalis Unigene: 22393 Human Unigene: 28549 Mouse Unigene: 7540 Xenopus laevis Important Note: This product as supplied is intended for research use only, not for use in human, therapeutic or diagnostic applications. |
| 产品图片 | ![]() Sample: Heart (Mouse) Lysate at 40 ug Brain (Mouse) Lysate at 40 ug Primary: Anti-Density Regulated Protein (bs-14276R) at 1/300 dilution Secondary: IRDye800CW Goat Anti-Rabbit IgG at 1/20000 dilution Predicted band size: 22 kD Observed band size: 22 kD ![]() Paraformaldehyde-fixed, paraffin embedded (Mouse brain); Antigen retrieval by boiling in sodium citrate buffer (pH6.0) for 15min; Block endogenous peroxidase by 3% hydrogen peroxide for 20 minutes; Blocking buffer (normal goat serum) at 37°C for 30min; Antibody incubation with (Density Regulated Protein) Polyclonal Antibody, Unconjugated (bs-14276R) at 1:400 overnight at 4°C, followed by operating according to SP Kit(Rabbit) (sp-0023) instructionsand DAB staining. |
风险提示:丁香通仅作为第三方平台,为商家信息发布提供平台空间。用户咨询产品时请注意保护个人信息及财产安全,合理判断,谨慎选购商品,商家和用户对交易行为负责。对于医疗器械类产品,请先查证核实企业经营资质和医疗器械产品注册证情况。
文献和实验Printing Low Density Protein Arrays in Microplates
Here, we provide methods for the creation of protein microarrays in microplates. The microplate consists of 96 wells with each well capable of holding a protein microarray at a spot density of up to 400 (20 � 20) individual elements. Arrays
Protein A Purification of Antibody
1. Reagents(1) Affi-gel Protein-A Agarose (BioRad #153-6153)(2) MAPS II Binding Buffer (BioRad # 153-6161)(3) 0.314 g/ml diH2O(4) MAPS II Elution Buffer (BioRad #153-6162)(5) 0.023 g/ml diH2O(6) MAPS II Regeneration Buffer (BioRad #153-6166(7) 1M
ANTIBODY BINDING TO PROTEIN A AND PROTEIN G
Protein A, derived from the cell wall of Staphylococcus aureus , and protein G, derived from the cell wall of certain strains of b -hemolytic Streptococcci , binds the Fc region
技术资料暂无技术资料 索取技术资料